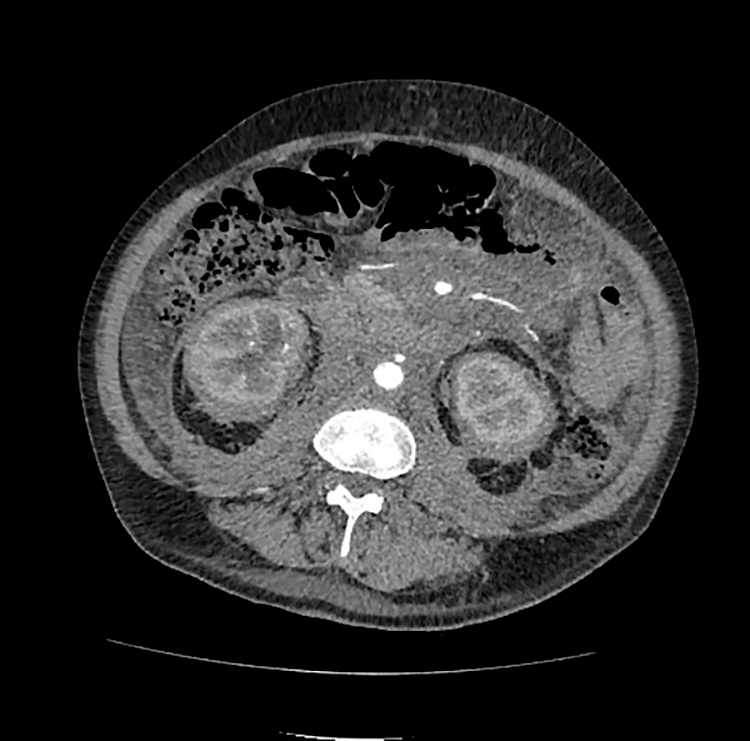
КТ брюшной полостии забрюшинного пространства

Сложный случай: Болезнь Эрдгейма-Честера, путь к диагнозу
Пациент Т. 61 г. проходил обследование в ГБУЗ ГКБ 52 ДЗМ г. Москвы с отечно-асцитическим синдромом неясного генеза, образованием забрюшинного пространства не верифицированной гистологической структуры. Правильно установить диагноз удалось спустя 2 года наблюдения пациента с момента появления первых симптомов, прибегнув к полному арсеналу лабораторно-инструментальных диагностических манипуляций.
В 2021 году пациент Т, 61 г., поступил на стационарное лечение в ГКБ г. Москвы с жалобами на выраженную полидипсию и полиурию, что привело к установлению диагноза «Несахарный диабет». После начала терапии десмопрессином состояние пациента улучшилось. Однако с апреля 2022 года пациент начал отмечать появление одышки при физической нагрузке, отеков нижних конечностей, увеличение живота и боли в грудной клетке. В другой ГКБ г. Москвы ему был выставлен диагноз «Непрерывно рецидивирующий перикардит». По данным гистологического исследования был выявлен реактивный экссудат с наличием единичных клеток мезотелия, проведено дренирование 5 литров серозной жидкости из полости перикарда. Пациент неоднократно госпитализировался на протяжении всего года с повторными жалобами на одышку и отеки.
В марте 2023 года в ГКБ г. Москвы пациенту была проведена видеоторакоскопия с выполнением биопсии перикарда, при этом злокачественные клетки не были выявлены, диагноз «Идиопатический перикардит» был подтвержден. Позже пациент амбулаторно консультировался у ревматолога, который выставили диагноз «Полиартериит с поражением легких».
В апреле 2023 года пациент вновь был госпитализирован в ГКБ г. Москвы с симптомами слабости правой и левой верхних конечностей, сухости во рту и общей слабости. Ему был поставлен диагноз «Ишемический инсульт в бассейне правой средней мозговой артерии». Также были выявлены объемное образование в полушарной щели и признаки лимфопролиферативного заболевания с поражением лимфатических узлов брыжейки, головного мозга и полисерозитом.
С 30 мая по 19 июня 2023 года пациент вновь проходил лечение в многопрофильном стационаре г. Москвы, где был выставлен диагноз: «Гипертензивная болезнь с застойной сердечной недостаточностью» и «Иммуноглобулин G4-ассоциированное лимфопролиферативное заболевание». У пациента были выявлены рецидивирующий экссудативный перикардит, двусторонний плеврит и обструктивный пиелонефрит, а также по КТ ОБП с контрастным усилением — объемное образование забрюшинного пространства с вовлечением парапанкреатической, паранефральной, парауретеральной клетчатки, с распространением вдоль сосудов брыжейки. Проведено несколько процедур дренирования плевральных полостей, перикарда, а также выполнена билатеральная нефростомия.
Вопрос о проведении диагностической биопсии брыжейки был рассмотрен, однако из-за тяжелого состояния пациента процедура не проводилась.
Пациент был выписан под амбулаторное наблюдение поликлиники. Для подтверждения диагноза иммуноглобулин-G4-ассоциированного заболевания был проведен анализ крови на иммуноглобулин G и G4, который дал отрицательный результат. Иммуногистохимическое исследование предыдущих биопсийных материалов (биопсия перикарда, выполненная 6 марта 2023 года в НИИ им. Н.В. Склифосовского) показало, что морфологическая картина соответствует идиопатическому перикардиту.
В июле-августе 2023 года пациент лечился в ГКБ № 52 с диагнозом «Новообразование неопределенного характера лимфоидной ткани».
При осмотре пациента: пациент поступил в состоянии средней тяжести. Имеются ксантомы передней поверхности грудной клетки, шеи, лба. Выраженные периферические отеки локализуются в области голеней и стоп. Органы дыхания, ССС, ЖКТ без отклонений. Обе нефростомы функционируют исправно.
Результаты клинико-лабораторных и инструментальных исследований при поступлении.
Лабораторные данные: лейкоциты 13,9×10^9/л, количество тромбоцитов — 322×10^9/л, С-реактивный белок (СРБ) — 10 мг/л, уровень холестерина — 6,3 ммоль/л, фибриноген — 6,0 г/л, альбумин — 29 г/л. Эти данные свидетельствуют о наличии умеренной воспалительной активности.
Компьютерная томография органов грудной клетки (КТ ОГК Плевральный выпот слева составляет 1180 мл, а в полости перикарда обнаружено 550 мл частично осумкованной жидкости вдоль правого предсердия. Диффузное уплотнение клетчатки вокруг восходящей части грудной аорты, сливающейся с аортой при нативном исследовании. Медиастинальные и аксиллярные лимфатические узлы не увеличены и четко не дифференцируются.
Эхо — КГ Визуализируется уплотнение корня аорты, колец и створок аортального и митрального клапанов. Незначительная митральная регургитация. Перикард уплотнен и несколько утолщен, в его полости содержится умеренное количество жидкости без признаков тампонады. В области верхушки сердца в полости перикарда обнаружено пристеночное гипер-изоэхогенное образование размером 0,7×2,6 см (вероятно тромб).
В области свободной стенки правого предсердия, с переходом на стенку правого желудочка и фиброзное кольцо трикуспидального клапана, визуализируется дополнительный неподвижный эхогенный фокус неоднородной эхогенности (преимущественно изоэхогенный с гипоэхогенным центром и гиперэхогенными включениями) с ровными контурами, размером около 2,1×2,8 см
Кроме того, в полости правого предсердия выявлены два округлых малоподвижных гипер-изоэхогенных образования размерами 1,6×2,1 см и 2,0×2,2 см, фиксированные к межпредсердной перегородке

1А 1Б
Рис. 1. КТ ОГК Поражение аорты, перикарда и периваскулярные муфты, 2023 год
КТ: Отмечается наличие муфтообразного утолщения ткани вокруг грудной аорты, умеренно накапливающей контрастное вещество, с максимальной выраженностью вокруг дуги аорты (рисунок 1а). Аналогичные периваскулярные муфты отмечаются вокруг коронарных артерий, преимущественно вокруг правой коронарной артерии (наружный диаметр муфты — 25 мм, просвет артерии — 3-5,5 мм) — рисунок 1б.
В нижней трети верхней полой вены (ВПВ) выявлено пристеночное утолщение протяженностью до 7,5 см и поперечным размером до 20 мм, которое распространяется в правое предсердие и умеренно накапливает контрастное вещество в венозную фазу. Наружный край ткани, пролабирующий в просвет, аваскулярен, возможно, покрыт тромботическими массами. В правом предсердии выявлен флотирующий фрагмент длиной около 27 мм и толщиной 10-12 мм.
Перикардиальные листки неравномерно утолщены (рисунок 1б), что, вероятно, обусловлено узловатой инфильтрацией. Между листками содержится небольшое количество жидкости, разделенной перегородками.
Кнаружи от правого предсердия наблюдается осумкованное жидкостное скопление линзообразной формы, толщиной до 5,8 см и объемом 480 мл (рисунок 1б)
Выявлена дополнительная ткань (инфильтрат? Объем?) забрюшинного пространства с вовлечением парапанкреатической, паранефральной, периуретеральной клетчатки, с распространением вдоль аорты и сосудов брыжейки. Двусторонний гидронефроз, обусловленный компрессией мочеточников и правой лоханки инфильтратом (рисунок 2)
Рис. 2. КТ брюшной полостии забрюшинного пространства, 2023 год
По совокупности находок и данных анамнеза заподозрена, как наиболее вероятная, болезнь Erdheim-Chester, в дифференциалном ряду — лимфома. Ретроперитонеальный фиброз маловероятен.
Для подтверждения данного предположения пациенту выполнена рентгенография трубчатых костей: выявлен островковый метафизарный и диафизарный склероз, в большей степени выраженный в большеберцовых костях (рисунок 3) — патогномоничный признак БЭЧ.
С учетом клинических признаков гипергидратации (периферические отеки, гидроторакс, гидроперикард), лабораторных данных (гипонатриемия, гипоосмолярность плазмы) и сохранной концентрационной функции почек, наличие несахарного диабета исключено.

Рис. 3. Поражение костей
С целью дальнейшего проведения иммуногистохимического (ИГХ) и молекулярно-генетического (BRAF-мутация) исследования, пациенту проведена трепан-биопсия костного мозга, биопсия кожных образований (ксантомы). По жизненным показаниям выполнена биопсия забрюшинного образования.
Во время ожидания результатов ИГХ исследования, а также в период предоперационной подготовки пациента к биопсии забрюшинного образования, мультидисциплинарным консилиумом принято решение о инициации терапии 1 линии — селективные блокаторы интерлейкиновых (ИЛ-1) рецепторов Анакинра 100 мг 1 раз в сутки подкожно, ежедневно с оценкой эффективности на 5-е сутки и дальнейшим решением вопроса о продолжении терапии.
На фоне проводимой терапии отмечается улучшение клинического состояния пациента: уменьшение одышки, сокращение объема отделяемого по плевральному дренажу и снижение потребности в респираторной поддержке. Дренаж из левой плевральной полости был удален.
По результатам трепанобиопсии костного мозга не получено данных, свидетельствующих о специфическом поражении, характерном для лимфомы или других форм гемобластозов.
Гистологическое исследование кожи, проведенное в специализированном центре, выявило картину, соответствующую неопухолевому дерматозу; опухолевый субстрат отсутствует.
Результаты биопсии лимфоузла забрюшинного пространства — наличие очагового инфильтрата из макрофагов с бобовидными/складчатыми ядрами, широкой эозинофильной цитоплазмой, примесью ксантомных клеток; определяется преимущественно периваскулярная рыхлая лимфоплазмоцитарная инфильтрация.
На срезах с парафинового блока проведено ИГХ-исследование 1848/23 с антителами к CD 138 (MI-15), CD68 (PG-M1), Ig G4 (MRQ 44/EP 1).
При иммуногистохимическом исследовании веретеновидные клетки и макрофаги экспрессируют ERK-1 (ядерно-цитоплазматическая реакция), CD68 (мембранная реакция). CD138+ немногочисленные разрозненно расположенные зрелые плазматические клетки.IgG4+единичные клетки, расположенные разрозенно.
Заключение: В исследованном материале данных в пользу IgG4-ассоциированного заболевания не обнаружено. Проведенное ИГХ-исследование позволило выявить популяцию активированных макрофагов, что не позволяет исключить субстрат не-лангергансоклеточного гистиоцитоза (болезнь Эрдхейма-Честера).
Трепан-биопсия костного мозга на молекулярно-генетическое исследование — выявлена гетерозиготная мутация гена B-RAF приводящая к аминокислотной замене V600E.
Таким образом, пациенту был выставлен диагноз:
Нелангергансоклеточный гистиоцитоз (синдром Эрдгейма-Честера) с поражением трубчатых костей (метафизарный и диафизарный склероз трубчатых костей голеней), поражением кожи (ксантомы), поражением сердца и артерий (периваскулярная инфильтрация аорты и ее ветвей, псевдоопухоль предсердия), поражение клетчатки забрюшинного пространства, средостения, брюшной полости, поражением почек, ЦВС.
Пациент был выписан на амбулаторный этап наблюдения. Принято решение об инициации терапии вемурафенибом 240 мг х 2 раза в день внутрь. С 20.10.2023 начата терапия. Пациент по данным Единой Электронной Медицинской карты продолжает амбулаторно прием вемурафениба на протяжении более года. Исходя из осмотров гематолога — явления дыхательной недостаточности не беспокоят. Эпизодов гипертермии нет. Выполнялись контрольные КТ ОГК и ОБП с контрастным усилением на фоне проводимой терапии —картина нелангергансоклеточного гистиоцитоза (болезнь Erdheim-Chester), положительная динамика на фоне лечения, с уменьшением выраженности периваскулярной инфильтрации аорты и ее ветвей, уменьшением инфильтрации забрюшинного пространства. Регресс признаков хронического экссудативного перикардита. Уменьшение (нормализация) размеров почек, двусторонний гидронефроз, обусловленный компрессией мочеточников и правой лоханки инфильтратом. Нефростомические дренажи с обеих сторон. Регресс перипортального отека (см. рис. 4-6).

Рис. 4. Циркулярная инфильтрация вокруг восходящего отдела аорты (аорта окружена муфтообразной тканью) — синдром «обложенной» аорты, coated aorta sign. Слева 2025 год, справа 2023 год.
Сагиттальная проекция.

Рис. 5. Утолщение паранефральных перегородок с обеих сторон по типу «волосатых» почек (“hairy” kidney). Слева 2025 год, справа 2023 год. Аксиальная проекция.

Рис. 6. Инфильтрация забрюшинной клетчатки, положительная динамика. Слева 2025 год, справа 2023 год. Аксиальная проекция.
Болезнь Эрдгейма-Честера (БЭЧ) — редкое мультисистемное гистиоцитарное заболевание, характеризующееся инфильтрацией тканей пенистыми гистиоцитами. Наиболее часто поражаются кости, но также могут вовлекаться сердце, почки, лёгкие, ЦНС и кожа. БЭЧ относится к группе L гистиоцитозов наряду с лангергансоклеточным гистиоцитозом и другими редкими формами. Ранее природа БЭЧ была неясной, однако открытие мутации BRAFV600E (выявляемой в 38–68% случаев) подтвердило её клональный, неопластический характер. Эта мутация активирует путь MAPK/ERK, способствуя аномальному росту клеток. БЭЧ сопровождается продукцией провоспалительных цитокинов и хемокинов, усиливающих местное воспаление. Заболевание было впервые описано в 1930 году, и к настоящему времени в мировой литературе зафиксировано около 800 случаев.
История болезни пациента демонстрирует пример сложного и многофакторного клинического случая, связанного с редким заболеванием — болезнью Эрдгейма-Честера. Диагностика болезни Эрдгейма-Честера затруднена из-за редкости заболевания и его неспецифичной клинической картины, которая охватывает широкий спектр симптомов — от эндокринных и легочных до сердечно-сосудистых и неврологических. У пациента предполагалось множество диагнозов, таких как идиопатический перикардит, лимфопролиферативное заболевание, гипертензивная болезнь с сердечной недостаточностью, и только после множества госпитализаций, диагностических процедур и повторных биопсий возникло предположение о болезни Эрдгейма-Честера. Такой диагностический путь усложняется необходимостью исключения других заболеваний с похожими симптомами, что требует проведения многочисленных лабораторных, иммуногистохимических и генетических исследований, даже с необходимостью участия нескольких мнений. Наш клинический случай подчеркивает важность мультидисциплинарного подхода в диагностике и лечении болезни Эрдгейма-Честера.